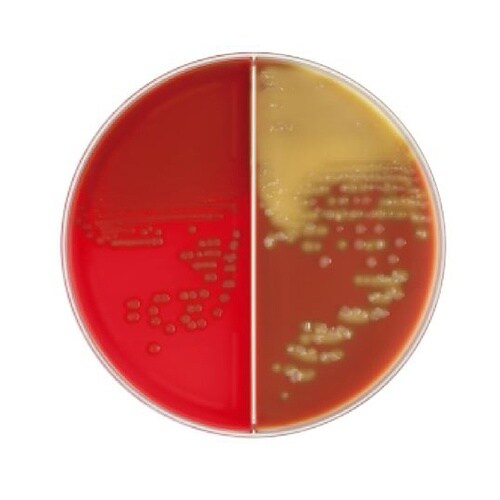
251302血液/チョコII寒天培地20枚

日本ベクトン・ディッキンソン
BD BBL(TM) TSAII5%ヒツジ血液寒天培地/チョコレートII寒天培地 20枚
【A052-1189】



| ¥7,388 (税込) / ¥6,717 (税抜) |
| ¥7,388 (税込) / ¥6,717 (税抜) |
| メーカー希望小売価格※税抜 (割引率) ¥7,070(4%) |
|---|
培地関連用品の売れ筋ランキング
- ¥3,135(税込) (税込) 〜
- ¥7,524(税込) (税込) 〜
- ¥11,547(税込) (税込) 〜
- ¥6,030(税込) (税込)
商品の特徴 |
本培地は、1枚で2種類の培地が併用できる様に組合わされた便利で効率の良い培地で、発育性、溶血反応にすぐれた一般分離用のTSAII5%ヒツジ血液寒天培地とHaemophilus、Neisseria など |
|---|---|
商品仕様 |
|
メーカー情報 |
|
カタログ掲載ページ |
-/- |
| 注意事項 | ※【返品に関するご注意】この商品は直送品のため、お客様のご都合による返品はお受けできません。 |
|---|